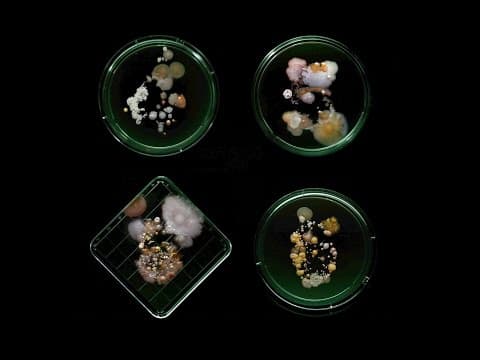
Subvisual Subway: The Art of New York City's Bacterial World - YouTube

The Culture and Landmarks of Copenhagen
By Knowledge - Cities of the WorldFrom boclips.com
677.9K views
47.2K likes
Copenhagen is a vibrant city known for its historical landmarks, world-class cuisine, and lively jazz music scene. Explore the city's cultural heritage by visiting iconic sites such as the Little Mermaid statue and navigating the city's famous canals. Taste the flavors of Danish cuisine and immerse yourself in the sounds of jazz at various clubs and international festivals.
Tags
Explainer
Physical Sciences
Geography and Earth Science
All ages
Comments
Leave a Comment
Comments are loading... If you don't see any, be the first to comment!
Related Videos
Lima from Above: Stunning Drone Views of Peru's Capital City
HoriZen
Discover the Vibrant City of Taipei
Knowledge - Cities of the World
Exploring Lisbon: Music, Festivals, and Delicious Cuisine
Knowledge - Cities of the World

Subvisual Subway: The Art of New York City's Bacterial World - YouTube
YouTube

Turkey Geography Country of Turkey
Owner - KLT
History of Louis Armstrong for Kids | Bedtime History
Bedtime History for Kids

Tiger Rag on a homemade Emphatic Chromatic Callioforte
Owner - The Kid Should See This

Countries and Capitals of the World - Learn Names of Capital Cities
Owner - Kiddopedia
Exploring the Exotic Cultural Flavors of Nepal
Knowledge - Food Stories

The Beautiful Relationship Between Physics and Jazz
Owner - The kid should see this